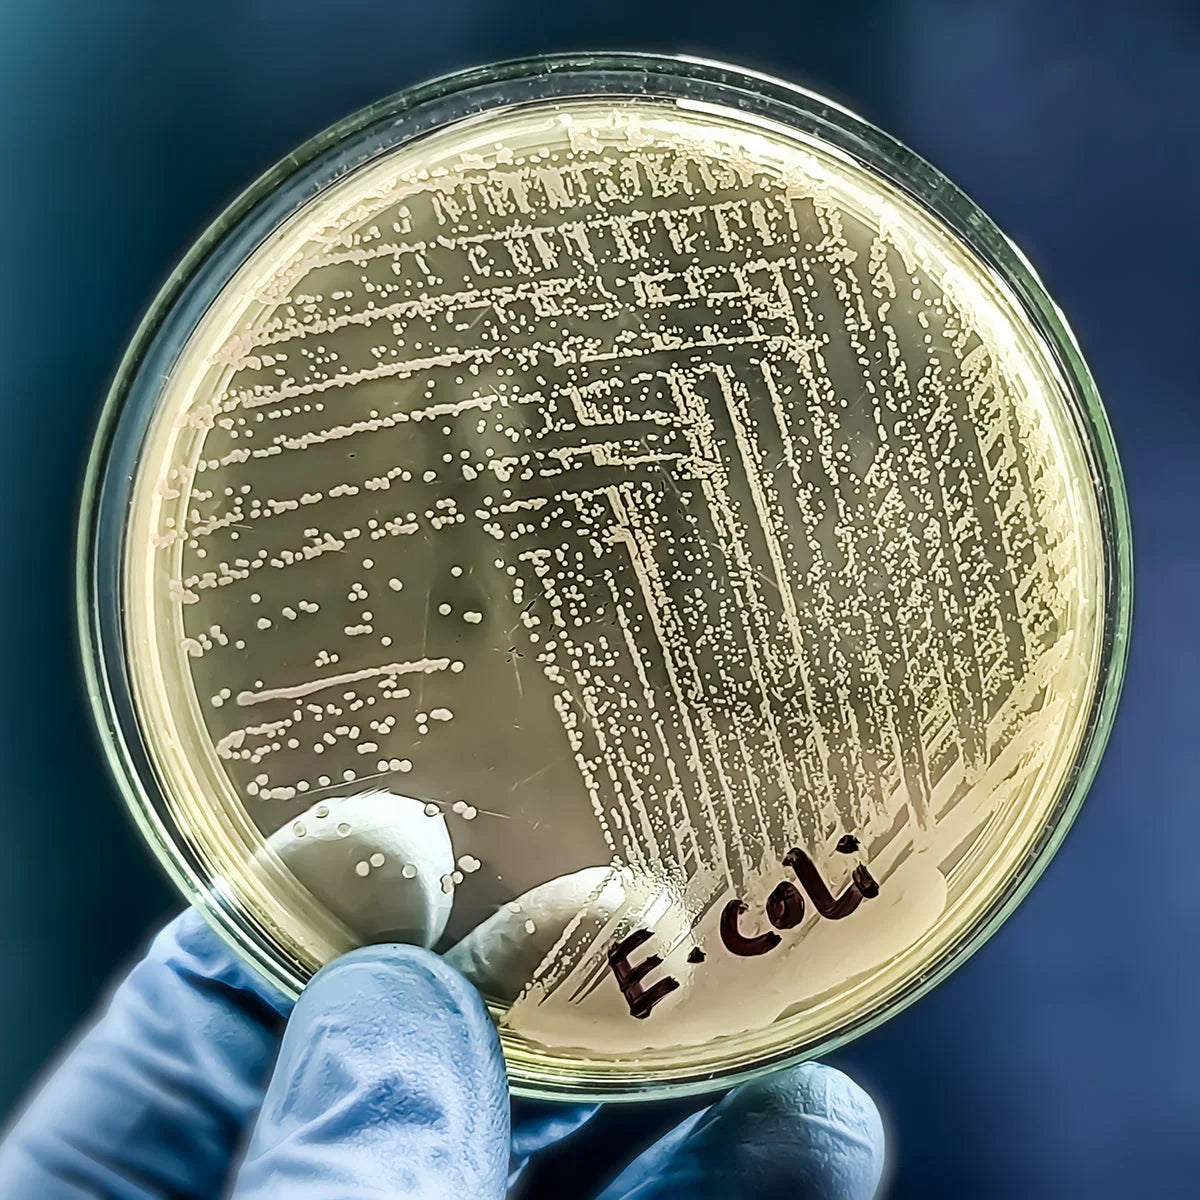

Mannavita D-manoza kompleks • z izvlečkom Brusnice • 90 kapsul
Hitro pošiljanje
BREZPLAČNA dostava nad 99€
HITRA dostava iz zaloge.
Garancija
30-dnevna Garancija Vračila Denarja!
Možnosti plačila

Kapsula Mannavita D-manoza vsebuje D-manozo, izvleček brusnice, origano, bambus in izvleček cimeta, kot tudi cink in probiotike.

Ti naravni aktivni sestavini delujeta sinergistično in okrepita učinke druga druge, da pomagata hitro in trajno odpraviti okužbe mehurja. [01.]
Aktivne sestavine v kapsuli Mannavita D-manoza preprečujejo, da bi se bakterije in glive pritrdile na steno mehurja, kar na koncu vodi do njihove odstranitve iz telesa in izginotja negativnih simptomov.
Za kaj je D-manoza koristna?
- Okužbe sečil, E. coli
- Želodčne in črevesne okužbe
- Izboljšanje delovanja jeter
Kemična struktura D-manoze je podobna celicam, ki se nahajajo na stenah sečil, zato se bakterije E. coli vežejo na molekule D-manoze namesto da bi se pritrdile na celice sečil. Ko se bakterije E. coli vežejo na D-manozo, se molekule skupaj z bakterijami izločijo iz telesa z urinom. Ta mehanizem na koncu vodi do odpraveinfekcije.
D-manoza je naravna snov, pridobljena iz brusnic. Telo je ne presnavlja, kar pomeni, da se ne pretvori v energijo, zato ima minimalen vpliv na raven krvnega sladkorja. Zaradi tega je varna za uporabo pri diabetikih. Ni znanih stranskih učinkov.
| Neto količina: | 90 kosov. |
| Konzistenca, Oblika: | kapsule |
| Velikost odmerka: | 3 |
| Število odmerkov na izdelek: | 30 |
☀Navodila za uporabo – za odrasle: 3 kapsule dnevno z veliko vode, 30 minut pred obroki ali 2 uri po obrokih.
☀ Navodila za uporabo – za otroke, mlajše od 14 let: 1–2 kapsuli dnevno z vodo, 2 uri po obroku.
Izdelek se lahko jemlje neprekinjeno brez prekinitev.
Priporočeni dodatni izdelki Mannavita skupaj z D-manozo za urinarne + prebavne okužbe:
- 100% brusnični sok
- Kapljice iz semen grenivke
- Koloidno srebro
- Colonum kapsule
Kapsulo D-mannose Mannavita lahko jemljete hkrati z zgoraj navedenimi pripravki.
Shranjevanje: Shranjujte na suhem mestu, zaščiteno pred svetlobo, pri temperaturi pod 25°C.
Hranilne vrednosti:
Aktivne sestavine v priporočenem dnevnem odmerku: 3 kapsule
| Količina v dnevnem odmerku | % Dnevna vrednost* | |
| D-manoza v prahu | 1350 mg | ** |
| Brusnica, 36:1 ekstrakt - (Vaccinium Macrocarpon) | 90 mg | ** |
| Izvleček Bambusa, silicija - (Bambusa Vulgaris) | 22,5 mg | ** |
| Cink | 2,25 mg | 22,5% * |
| List Origana, 4:1 izvleček - (Origanum Vulgare) | 1,5 mg | ** |
| Cimetova skorja, 30:1 izvleček - (Cinnamomum Zeylanicum) | 0,51 mg | ** |
| L. Acidophilus, 200 B/g | 3 milijarde bakterij | ** |
* PDV % = odstotek priporočenega dnevnega vnosa za odrasle
** Dnevna vrednost ni določena.
Pogoji, pri katerih je priporočljivo jemati D-manozo:
| ✓ Okužbe sečil |
| ✓ Okužba z E. coli |
| ✓ Bakterijske črevesne okužbe |
| ✓ Okužbe želodca |
| ✓ Vaginalna glivična okužba |
| ✓ Po zdravljenju z antibiotiki |
| ✓ Slabost jeter |
| ✓ Oslabljena črevesna flora |
| ✓ Napihnjenost, črevesni plini |
| ✓ Driska |
Učinki D-manoze proti E. coli pri urinarnih in prebavnih okužbah

Bakterije E. coli povzročijo 90 % okužb sečil. Te bakterije se pritrdijo na receptorje na površini celic, ki obdajajo mehur in sečnico, kar jim omogoča, da kolonizirajo sečila in povzročijo okužbo. Kemična struktura D-manoze je zelo podobna tem receptorjem, zato se, ko D-manoza vstopi v sečila, bakterije E. coli vežejo na molekule D-manoze namesto na celice sečil.
Ko se bakterije E. coli pritrdijo na D-manozo, se izločijo iz telesa z urinom. To pomaga očistiti sečila bakterij, zmanjša resnost okužbe in spodbuja celjenje. D-manoza tako ponuja učinkovit, neantibiotični pristop k zdravljenju in preprečevanju okužb sečil.
Bakterije E. coli in njihov vpliv na okužbe želodca in črevesja
Bakterije E. coli lahko povzročijo tudi želodčne in črevesne okužbe, ki lahko vodijo do driske ali vnetja črevesja. Podobno kot pri okužbah sečil se te bakterije lahko pritrdijo na celice črevesne stene in povzročijo vnetje. D-manoza deluje tudi v želodcu in črevesju ter preprečuje, da bi se E. coli pritrdila, s čimer omogoča njeno odstranitev. Bakterije, vezane na D-manozo, zapustijo prebavni sistem z blatom. [02.]
Učinki brusnice, cinka, origana, cimeta in L. Acidophilus na okužbe sečil
Brusnica, izvleček bambusa in cink vsi prispevajo k preprečevanju in zdravljenju okužb sečil prek različnih mehanizmov. Ko se uporabljajo skupaj, imajo ti sestavni deli močnejši učinek kot če jih jemljemo posamezno. Njihovo skupno delovanje bistveno zmanjša resnost okužb sečil in zmanjša možnost ponovitve.
Brusničine antioksidativne spojine pomagajo zmanjšati vnetje in oksidativni stres v sečilih, do katerih lahko pride med okužbami. To podpira lajšanje simptomov in pomaga ohranjati zdravje sečil.
Izvleček bambusa je bogat s silicijevim dioksidom, ki je bistven za regeneracijo tkiv in zdravje celic. Čeprav nima neposrednih antibakterijskih lastnosti, silicijev dioksid pomaga ohranjati strukturno celovitost sečil ter krepi njihovo odpornost proti okužbam.
Cink ima pomembno vlogo pri regeneraciji celic in celjenju ran, kar je lahko še posebej koristno po okužbi sečil, ko so lahko tkiva sečil poškodovana. [03.]
Lastnosti Mannavita D-manoze
| Sinergijski učinek | da |
| Visoka vsebnost učinkovine | da |
| Brez GSO | da |
| Izdelano v Evropi | da |
| Brez nepotrebnih veziv | da |
| Učinek nastopi v 2–3 dneh | da |
| Oblikovano za optimalno absorpcijo | da |
| Prijazno za keto | da |
| Prijazno paleo prehrani | da |
| Dieta z nizko vsebnostjo ogljikovih hidratov | da |
| Postenje | da |
| Vegansko / Vegetarijansko | da |
| Visok krvni tlak | da |
| Diabetes | da |
| Avtoimunske bolezni | da |
Opozorila: To prehransko dopolnilo ni nadomestilo za raznovrstno prehrano in zdrav način življenja. Hranite izven dosega otrok. Ne prekoračite priporočenega dnevnega odmerka.
-
Zdravstvene težave in telesna stanja, za katera priporočamo, da jih vključite v terapijo:
-
Prebavni sistemH. Pylori • Driska • Napihnjenost in plini
-
Ledvice, sečilaOkužba z E.coli • Prekomerno aktiven mehur • Vnetje mehurja • Urinska inkontinenca • Rak mehurja • Hidronefroza • Ledvična odpoved • Ledvična cista • Ledvični kamni • Rak ledvic
Ta izdelek se lahko uporablja med naslednjimi dietami:
Ta izdelek vsebuje naslednje alergene: